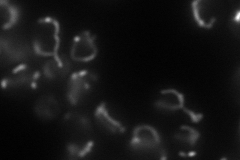
YIL022W

View description
Essential component of the Translocase of the Inner Mitochondrial membrane (TIM23 complex); tethers the import motor and regulatory factors (PAM complex) to the translocation channel (Tim23p-Tim17p core complex)
Localization:
Intensity:
Fold change:
Significance:
-
C’ GFP library in SD

below threshold14.53 -
N' NOP1pr-GFP in SD
mitochondria82.6247 -
N' TEF2pr-mCherry in SD

mitochondria0 -
N' NATIVEpr-GFP in SD

missing0 -
N' TEF2pr-VC and Cyto-VN in SD

#N/A0 -
C’ GFP library in SD+DTT

cytosol15.161.04No -
C’ GFP library in SD+H2O2

cytosol13.770.94No -
C’ GFP library in Starvation Media

cytosol17.961.23No -
C’ GFP library on the background of Pup2-DaMP

below threshold -
C’ GFP library on the background of CCT mutant

below threshold12.61790.868187No
